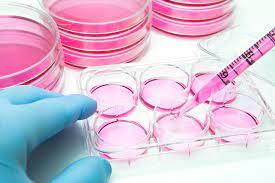
The global cell culture market is being driven by the increased prevalence of cancer and cardiovascular illnesses cell culture market

The global cell culture market is being driven by the increased prevalence of cancer and cardiovascular illnesses. The biological products derived from cell culture are utilised to treat various disorders. Technological advancements in the pharmaceutical business are offering prospective income opportunities for cell culture market participants. Market expansion is being accelerated by increased expenditure in R&D in cell culture to discover creative solutions for the treatment of various disorders in the body. Players in the market are experimenting with novel ways to culture or use cells for a variety of applications.
The cell culture market is being fueled by the rapid expansion of pharmaceutical businesses, growth and advancement in drug development and discovery, and rapidly developing clinical research institutes in developed nations. The worldwide cell culture market's expansion is being hampered by high costs and a lack of sufficient infrastructure for research operations.
Demand for biopharmaceuticals is on the rise, which is boosting market growth.
Cell culture technology has been found to be useful and efficient in the biopharmaceutical sector due to the increasing demand for biosimilar and biologic medicines for the treatment of cancer and other chronic and cardiovascular illnesses. By cutting manufacturing costs, cell culture products boost productivity. Cell culture is the extraction of cells from an animal or plant source and their application in the development of biosimilar or biologic therapies.
These cells may be stored and grown in a temperature, gas, pH, and humidity-controlled environment. These elements are necessary for cell development and proliferation. Before cultivating the cells, they might be removed mechanically or enzymatically. The cells to be cultivated can alternatively be obtained from a previously established cell line or cell strain. In North America and Europe, biosimilar products have exploded in popularity. This element aids in the expansion of the worldwide cell culture industry.
